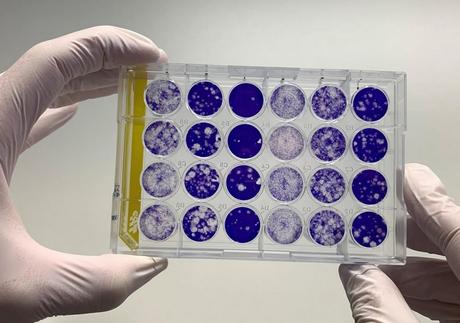
Les anticorps anti-coronavirus durent au moins 3 mois après l'infection à SARS-COV-2 ? (Visuel Fotolia) Les anticorps anti-coronavirus durent au moins 3 mois après l'infection à SARS-COV-2 ? (Visuel Fotolia)

C'est une nouvelle estimation de la durée de la présence d'anticorps détectables dans le sang et la salive, post-COVID-19. Avec une conclusion encore différente : les anticorps anti-coronavirus durent au moins 3 mois après l'infection, selon cette équipe de l’Université de Toronto après de multiples analyses d’échantillons de salive et de sang de patients COVID-19 suivi depuis l'apparition des premiers symptômes. L’étude, publiée dans la revue Science Immunology, estime ainsi que les anticorps de la classe IgG qui se lient à la protéine de pointe du SRAS-CoV-2 sont détectables pendant au moins 115 jours. Autre conclusion, ces anticorps peuvent tout à fait être détectés dans la salive, ce qui confirme la faisabilité de tests salivaires.
Les anticorps IgG contre la protéine de pointe du virus sont donc relativement durables dans le sang et la salive, résume l’auteur principal, Jennifer Gommerman, professeur d'immunologie à l'Université de Toronto et responsable des tests de salive. L’auteur souligne que si la salive n’est pas aussi sensible que le sérum, elle présente l’énorme avantage d’être facile à collecter et représente dans ce cas une bonne alternative pour les tests d'anticorps.
Des IgG contre la protéine de pointe du virus relativement durables
L’équipe a examiné la réponse en anticorps anti-SRAS-CoV-2 sur une période de 115 jours dans le sérum de 439 patients et dans la salive de 128 patients atteints de COVID-19 vs témoins.
- Les IgG (immunoglobulines de type G) spécifiques de l'antigène dans les deux fluides ont été détectées au maximum après 16 à 30 jours après apparition des symptômes et sont restées stables jusqu’à 105 à 115 jours après apparition des symptômes.
- Les IgM et IgA spécifiques de l'antigène ont été rapidement induites mais diminuent ensuite beaucoup plus rapidement dans le sérum et la salive. Dans le sérum, ces anticorps atteignent un maximum à 31–45 jours après apparition des premiers symptômes puis diminuent lentement jusqu'à 105 jours, avec une baisse plus prononcée entre le 105è et le 115è après l’apparition des symptômes ;
- cependant, les niveaux d'IgG et d'IgM spécifiques de l'antigène s’avèrent fortement corrélés dans les échantillons de sérum et de salive appariés ce qui suggère que la salive peut être utilisée, à la place du sérum, pour surveiller la réponse immunitaire à l'infection par le SRAS-CoV-2 ; globalement, ces résultats indiquent que
la réponse en anticorps IgG à l’infection à SRAS-CoV-2 se maintient sur une période d’au moins 3 mois.
Une nouvelle plate-forme mise au point au Lunenfeld-Tanenbaum Research Institute (LTRI, Toronto) pour la détection des anticorps dans le sérum ou le sang a permis ces recherches et va contribuer au contrôle de l’infection. La durabilité de la réponse des anticorps au SRAS-CoV-2 a fait l’objet de nombreuses études ces dernières semaines.
Ces nouvelles conclusions soutiennent une réponse par anticorps plus durable à l'infection par le SRAS-CoV-2 et la faisabilité d’un vaccin ayant le potentiel d'induire une réponse anticorps suffisamment durable.
Source: Science Immunology 08 Oct 2020 DOI: 10.1126/sciimmunol.abe5511 Persistence of serum and saliva antibody responses to SARS-CoV-2 spike antigens in COVID-19 patients
Lire aussi :
- COVID-19 : Après la première vague, l’immunité humorale reste faible
- COVID-19 : L’immunité ne dure que 3 mois
